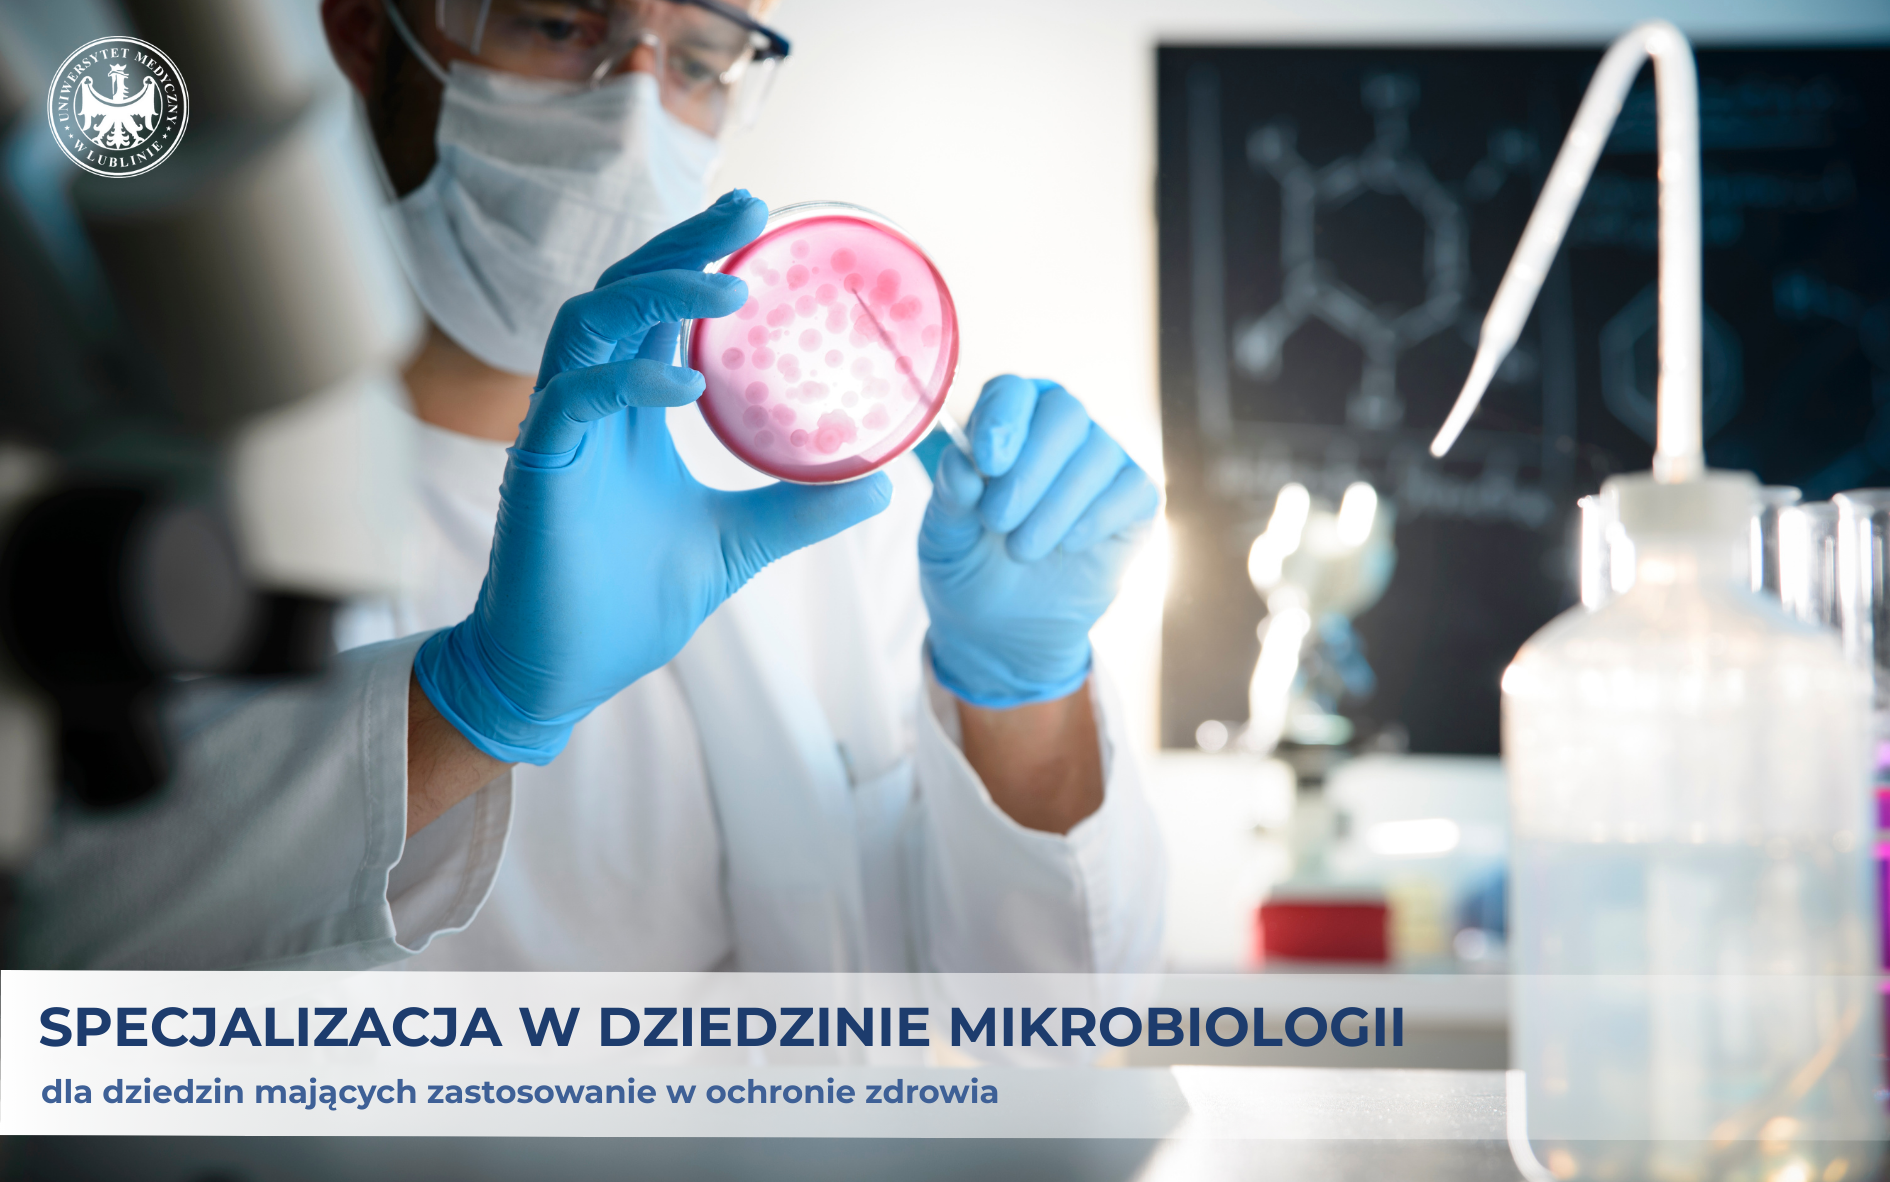

Kategoria: Post
Informujemy, że Nasza Uczelnia jako jedyna w Polsce uzyskała akredytację do prowadzenia szkolenia specjalizacyjnego z mikrobiologii dla dziedzin mających zastosowanie w ochronie zdrowia.
Kategoria: Post
Informujemy, że Nasza Uczelnia jako jedyna w Polsce uzyskała akredytację do prowadzenia szkolenia specjalizacyjnego z mikrobiologii dla dziedzin mających zastosowanie w ochronie zdrowia.
Dodano: 15-05-2025
Dodano: 15-05-2025
Informujemy, że Nasza Uczelnia jako jedyna w Polsce uzyskała akredytację do prowadzenia szkolenia specjalizacyjnego z mikrobiologii dla dziedzin mających zastosowanie w ochronie zdrowia.
Liczba miejsc: 20
Osoba ubiegająca się o odbywanie szkolenia specjalizacyjnego składa, za pomocą SMK, do wojewody właściwego ze względu na obszar województwa, na terenie którego zamierza odbywać szkolenie specjalizacyjne, wniosek o rozpoczęcie tego szkolenia.
Nabór na specjalizacje prowadzi Wydział Zdrowia Urzędu Wojewódzkiego w Lublinie.
Termin składania wniosków od dnia 01.05.2025 r. do 31.05.2025 r.
Postępowanie kwalifikacyjne od dnia 01.06.2025 r. - 30.06.2025 r.
O wyniku postępowania kwalifikacyjnego wojewoda zawiadamia, za pomocą SMK, osobę ubiegającą się o odbywanie szkolenia specjalizacyjnego.
Program specjalizacji w dziedzinie z mikrobiologii dla osób posiadających tytuł zawodowy magistra lub magistra inżyniera lub równorzędny uzyskany na kierunku studiów w zakresie biologii, biotechnologii, mikrobiologii (Program)
Ustawa o uzyskiwaniu tytułu specjalisty w dziedzinach mających zastosowanie w ochronie zdrowia (Ustawa)
Kontakt w celu uzyskania szczegółowych informacji:
mikrobiologia.lekarska@umlub.pl, tel.: 81 448 6400/ 6402
mgr Magdalena Fidecka-Skwarzyńska, tel.: 81 448 5122

CKP
Centrum Kształcenia Podyplomowego


© 2012 - 2026 - ITEM - Wszystkie prawa zastrzeżone.
Developer : inż. Marcin Czochra
ITEMRED : v.1.2